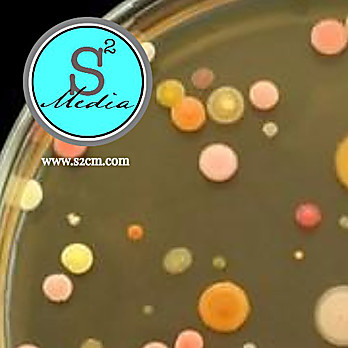

Reasoner'S 2a Agar (R2a), 16x90mm Plate, Pack Of 10
$ 19.16
|
|
Details:
Additional info recommended for the enumeration of heterotrophic organisms found in treated potable waterthe low nutrient content medium promotes growth of stressed or damaged bacteria in conjunction with lower incubation temperatures and longer incubation timesour manufacturing facility and qsm comply with cgmp's for medical device manufacturingstackable, anti-slip plates are packaged in sleeves of 10 in breathable cellulose bagsplease note: s2 media items have a 2 pack minimum order quantity requirement.Reasoner's 2a agar (r2a)
Additional Information
| SKU | 5289167 |
|---|---|
| UOM | Pack of 10 |
| UNSPSC | 41106200 |
| Manufacturer Part Number | 5003 |
